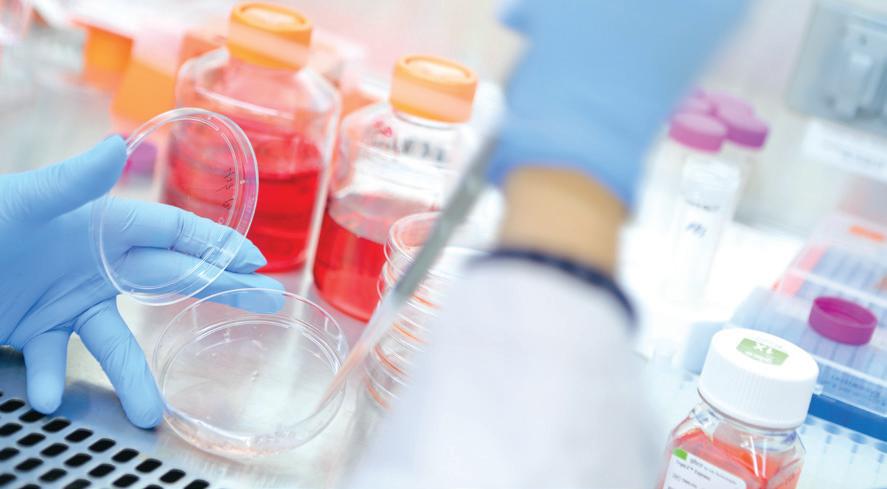

Education TRAINING
THE NEXT GENERATION OF LEADERS
Advanced Graduate Degree Programs
The four-year predoctoral DMD program and curriculum reflects Penn Dental Medicine’s commitment to both oral science and oral health care. Beginning in the first year of study, basic sciences and clinical experiences are closely linked, while early involvement in practice settings helps students integrate classroom instruction with delivering evidence-informed, patient-centered clinical care. Students can pursue added study in areas of interest through a competitive honors program in research and a variety of clinical specialties. And, close ties with other Penn schools allow for dynamic dual-degree options for those exceptional DMD students able to meet the application standards of both programs.
Graduate Dental Education Programs
Postgraduate students can complete specialty training in endodontics, oral medicine, oral and maxillofacial surgery, orthodontics, pediatrics, periodontics, periodontics/ orthodontics, and prosthodontics.
Program for Advanced Standing Students (PASS)
The two-and-a-half year PASS program enables graduates of foreign dental schools to earn a DMD, allowing them to take licensing exams in any U.S. state. PASS students are fully integrated into the predoctoral class, joining the second-year class in January.
Biodental Consortial Programs
Qualified high school students may apply to accelerated programs at four participating universities, leading to a combined bachelor’s and dental degree in seven years. Accepted students enter Penn Dental Medicine after their third year of undergraduate study and receive a bachelor’s degree from their undergraduate institution after completing the first year at Penn Dental Medicine.
Continuing Dental Education
An ADA CERP-recognized provider of continuing education, Penn Dental Medicine offers robust programming of online and in-person courses and symposia.
• Master of Science in Oral Biology (MSOB), designed for students who are interested in integrating extensive research into their education. Individuals can pursue a MSOB concurrently with a graduate dental education specialty program, as a dual degree in conjunction with a DMD or, independently.
• Doctor of Science in Dentistry (DScD), preparing students to successfully enter the field of academic dentistry as clinical or basic science researchers. It can be pursued concurrently with a specialty program certificate or independently.
• Master of Oral Health Sciences (MOHS) for both predental track students looking to enhance their credentials for applying to a DMD/DDS program and another track for non-U.S.-trained dentists preparing to successfully apply to a U.S. dental school.
• Master of Advanced Dental Studies (MADS), a oneyear hybrid program that includes both synchronous and asynchronous online courses as well as oncampus clinical rotations, is directed to both domestic and international dentists. Offered in seven clinical specialties, MADS is designed for clinicians who wish to enhance their knowledge in a clinical discipline or improve their qualifications when applying to U.S. residency programs. The program also serves international dentists with U.S. specialty degrees whose home country requires a Master’s degree for recognition of the specialty.
• Master of Science in Oral and Population Health (MOPH), an online program (synchronous and asynchronous) that provides students access to state-of-the-art information, knowledge, and skills in population health, focusing on oral health as an essential component of overall health and well-being. Students interact and learn from world-renowned leaders in population health research and evidenceinformed policies, providing a diversity of disciplines, contexts, research methods, and cultures.
Robust Research Enterprise
Patient Care SERVING THE COMMUNITY, VULNERABLE POPULATIONS
Clinical Care Centers at Penn Dental Medicine
Penn Dental Medicine students and faculty are a major provider of clinical care to residents of West Philadelphia and the Philadelphia community at large. A full range of general and specialty services are provided at Penn Dental Medicine, including treatment for medically complex patients, persons with disabilities, and other vulnerable populations. The teaching clinical care centers within the School include:
• Predoctoral Comprehensive Care clinics (Robert I. Schattner Clinic and Henry Schein Cares Clinic)
• Brainerd F. Swain Orthodontic Clinic
• Syngcuk Kim Endodontic Clinic
• Oral Surgery Clinic
• Saito Pediatric Clinic
• The Sarmiento Center for Periodontics
• William W.M. Cheung Advanced Dental Care Clinic
• Personalized Care Suite, clinical arm of the Penn Dental Medicine Care Center for Persons with Disabilities, serving medically complex patients and persons with disabilities
• Vulnerable Populations Clinic, serving refugees, survivors of psychological and physical violence, and intimate partner violence
Penn Dental Family Practice
Penn Dental Medicine also operates two group, interdisciplinary care practices through the Penn Dental Family Practice. These practice locations serve faculty and staff of the University of Pennsylvania and the Health System, as well as the general public. The locations include:
Locust Walk University City 240 South 40th Street 3737 Market Street 3rd Floor 10th Floor Philadelphia, PA 19104 Philadelphia, PA 19104
Community Care Centers
Students and faculty treat patients in local community settings via:
• Penn Dental Medicine at Puentes de Salud, serving the Latino immigrant community at 1700 South Street
• Penn Dental Medicine at Mercy LIFE, serving the elderly in West Philadelphia
• PennSmiles, serving children at Philadelphia schools, Head Start programs, and other neighborhood sites
• Penn Dental Medicine at Woods Mikey Faulkner Dental Care Center, serving children and adults with disabilities and acquired brain injuries at Woods Services Langhorne, PA-based campus
• Penn Dental Medicine at PHMC Health Campus on Cedar – serving the community as part of this public health center at 54th St. and Cedar Ave.
MISSION STATEMENT
To transform global oral health and well-being through exceptional clinical care, innovation, education, and research.
CORE VALUES
Penn Dental Medicine LEADS (Legacy, Empowerment, Aspiration, Discovery, Social Consciousness)
VISION & PHILOSOPHY
• Foster a humanistic environment where each individual in our community is valued, respected and empowered.
• Treat our patients with compassion and respect, and provide exceptional evidence-based care.
• Honor Penn Dental Medicine’s legacy through transformative initiatives to solve the complex problems of today and tomorrow.
• Shape the global dental profession by teaching evidencebased knowledge and providing opportunities to pursue individualized development for life-long learning.
• Promote interdisciplinary collaborations that accelerate innovation and scientific discovery to address unmet needs in health.
• Mentor exceptional leaders in education, research and oral health.
School Leadership
Mark S. Wolff, DDS, PhD Morton Amsterdam Dean
Faizan Alawi, DDS
Vice Dean, Academics
Hydar Ali, PhD
Associate Dean, Faculty Development & Mentorship
Markus Blatz, DMD, PhD, Prof Dr med dent
Assistant Dean, Digital Innovation & Professional Development
Kathleen Boesze-Battaglia, PhD
Assistant Dean, Academic Initiatives
Bruce Brandolin, DDS
Assistant Dean, Intramural Practice & External Partnerships
Yu Cheng Chang, DDS, MS, DMD
Assistant Dean, Emerging Technology in Patient Care
Modupe Coker, BDS, MPH, PhD
Assistant Dean, Clinical & Translational Research
Maren Gaughan
Associate Dean, Development & Strategic Initiatives
Marco Georeno
Associate Dean, Finance & CFO
Dana Graves, DMD, DMSc Vice Dean, Research & Scholarship
Uri Hangorsky, DDS, MS
Associate Dean, Student Affairs
Sean C. Meehan, DMD
Assistant Dean, Office of Clinical Affairs, Chief Dental Officer
Mark Mitchell
Associate Dean, Admissions
Brian Myers
Senior Associate Dean, Development & Alumni Relations
Sinem Esra Sahingur, DDS, MS, PhD
Associate Dean, Graduate Studies & Student Research
Frank Setzer, DMD, MS, PhD
Associate Dean, Clinical Affairs
Thomas P. Sollecito, DMD
Associate Dean, Hospital & Extramural Affairs
Melanie Sposa
Executive Director, Human Resources
Kim Wolcott
Associate Dean, Administration, Chief of Staff
Department Chairs
BASIC & TRANSLATIONAL SCIENCES
Robert P. Ricciardi, MA, PhD
Acting Chair
Henry Daniell, PhD Vice Chair
ENDODONTICS
Bekir Karabucak, DMD, MS Chair
ORAL MEDICINE
Thomas Sollecito, DMD, FDS, RCSEd Chair
ORAL & MAXILLOFACIAL SURGERY & PHARMACOLOGY
Anh D. Le, DDS, PhD Chair
ORTHODONTICS
Chun-Hsi Chung, DMD, MS Chair
PERIODONTICS
Dana Graves, DMD, DMSc Interim Chair
PREVENTIVE & RESTORATIVE SCIENCES
Markus B. Blatz, DMD, PhD, Prof Dr med dent Chair
David Hershkowitz, DDS, AAS
Associate Chair, Division of Community Oral Health
DIVISION OF COMMUNITY ORAL HEALTH
Ryan Richard Ruff, PhD, MPH Division Chief
DIVISION OF PEDIATRIC DENTISTRY
Betty Hajishengallis, DMD, DDS, PhD, MSc Division Chief
DIVISION OF PROSTHODONTICS
Nupur Patel, BDS, DMD, MS, FACP Division Chief
DIVISION OF RESTORATIVE DENTISTRY
David Hershkowitz, DDS, AAS Division Chief
Center Directors
CARE CENTER FOR PERSONS WITH DISABILITIES
Miriam Robbins, DDS, MS Director
Alicia Risner-Bauman, DDS, FADPD, DABSCD Associate Director
Temitope Omolehinwa, BDS, DMD, DScD Associate Director
CENTER FOR CLINICAL & TRANSLATIONAL RESEARCH
Modupe Coker, BDS, MPH, PhD
Assistant Dean, Clinical & Translational Research
CENTER FOR INNOVATION & PRECISION DENTISTRY (CiPD)
Michel Koo, DDS, PhD Co-Founding Director
CENTER FOR INTEGRATIVE GLOBAL ORAL HEALTH (CIGOH)
Michael Glick, DMD Executive Director
COCHRANE ORAL HEALTH
COLLABORATING CENTER AT PENN DENTAL MEDICINE
Alonso Carrasco-Labra, DDS, MSc, PhD Director
Board of Advisors
David Tai-Man Shen, D’79 GD’81, Chair
Ruchi Aggarwal Goel, WG’04
Stanley M. Bergman, Emeritus
Dirk Brunner, MSC, MBA
Julie Charlestein
William W. M. Cheung, D’81 GD’82, Emeritus
Joanne Chouinard-Luth, D’79
Terri Dolan, DDS, MPH
Egidio Farone, D‘84
Allen Finkelstein, DDS
Anne Koch, D’77 GD’93
David Kochman
Myechia Minter-Jordan, MD
Vincent Mosimann
Catherine O’Hern Lyons, C’86
Joan O’Shea, MD
Garry Rayant, GD’77
Daniel Richardson, D’02
Maria Ryan, DDS, PhD
Tony Saito, D’95
Hector Sarmiento, GD‘14
Thomas Schwieterman, MD
Heather Trombley
Joerg Vogel
Robert Zou, WG’94
EX OFFICIO MEMBERS
Gail E. Schupak, D’83, Chair, Dean’s Council
Alyssa Greenberger, D’02, President, Alumni Society